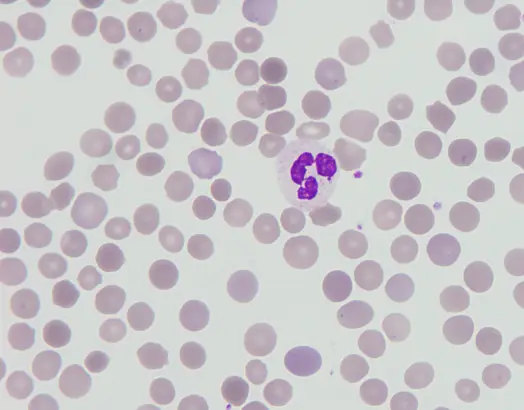
圖片描述

110年:醫學三(1)
一位 18歲男性,因為輕微黃疸而來門診求醫。身體診察除了鞏膜泛黃之外,並無其他異常。患者血液數據顯示:白血球 10,000/μL ,分類無明顯異常,血紅素 13.3 g/dL , MCV ( mean corpuscular volume ) 84.5 fL ,MCHC( mean corpuscular hemoglobin concentration ) 37.0 g/dL ,血小板 218,000/μL ,總膽紅素輕微升高 4.63mg/dL,直接膽紅素 0.77 mg/dL , lactate dehydrogenase ( LDH ) 173 U/L (參考區間 140 ~ 271 ),而 haptoglobin是< 30 mg/dL(參考區間 44 ~ 215 )。自體免疫相關的檢查無異常。 Direct Coombs’ test 與 indirect Coombs’ test都是 negative。其血液抹片如下圖所示。病人平時健康狀況良好,但是有膽結石。他的爸爸與祖父也有類似症狀與臨床表徵。以下關於這位病人最可能的疾病之診斷與治療,何者錯誤?
A這個病人主要是血管內的溶血
B脾臟切除是緩解這類病人之症狀的方式,但是必須小心使用,非嚴重的狀況,不建議使用
C感染常會加劇此病人之臨床症狀,例如黃疸與貧血
D此類疾病緣起於 RBC membrane-cytoskeleton 之異常
詳細解析
本題觀念:
Hereditary spherocytosis (HS) 屬於因紅血球膜—骨架蛋白異常所引發之先天性溶血性貧血;病因包括 spectrin、ankyrin、band 3、protein 4.2 等蛋白突變,造成 RBC 變形能力下降,主要經由 spleen 內巨噬細胞清除異常 RBC,屬 extravascular hemolysis。典型實驗室特徵為高 MCHC、高 RDW、間接 bilirubin 上升、LDH 輕度變化、haptoglobin 下降;Coombs 測試陰性,周邊血抹片見 spherocytes。
影像分析:
周邊血抹片可見:
- 紅血球中央淡色區消失,細胞形態由正常圓盤狀變為小而緻密的球形(spherocytes)。
- 細胞尺寸普遍較正常 RBC 小(MCV 正常但呈高 MCHC)。
- 可見少量 polychromasia,顯示骨髓代償性生成網狀紅細胞。
此形態符合 HS 中膜—骨架蛋白缺陷導致之形態改變與脾臟過濾移除機制。
選項分析
- 選項A 這個病人主要是血管內的溶血
Hereditary spherocytosis 乃因 spleen 巨噬細胞清除變形 RBC 而引起,屬 extravascular hemolysis。若為 intravascular hemolysis,實驗室會見明顯
...(解析預覽)...
![醫師[2] - 貧血及紅血球疾病 - AI 圖文解析預覽](/_next/image?url=https%3A%2F%2Fbgvxfcrmbdvefjhuvrmt.supabase.co%2Fstorage%2Fv1%2Fobject%2Fpublic%2Fvisual-explanations%2F207%2F8845_taf758525.webp&w=1920&q=75)
升級 VIP 解鎖圖文解析